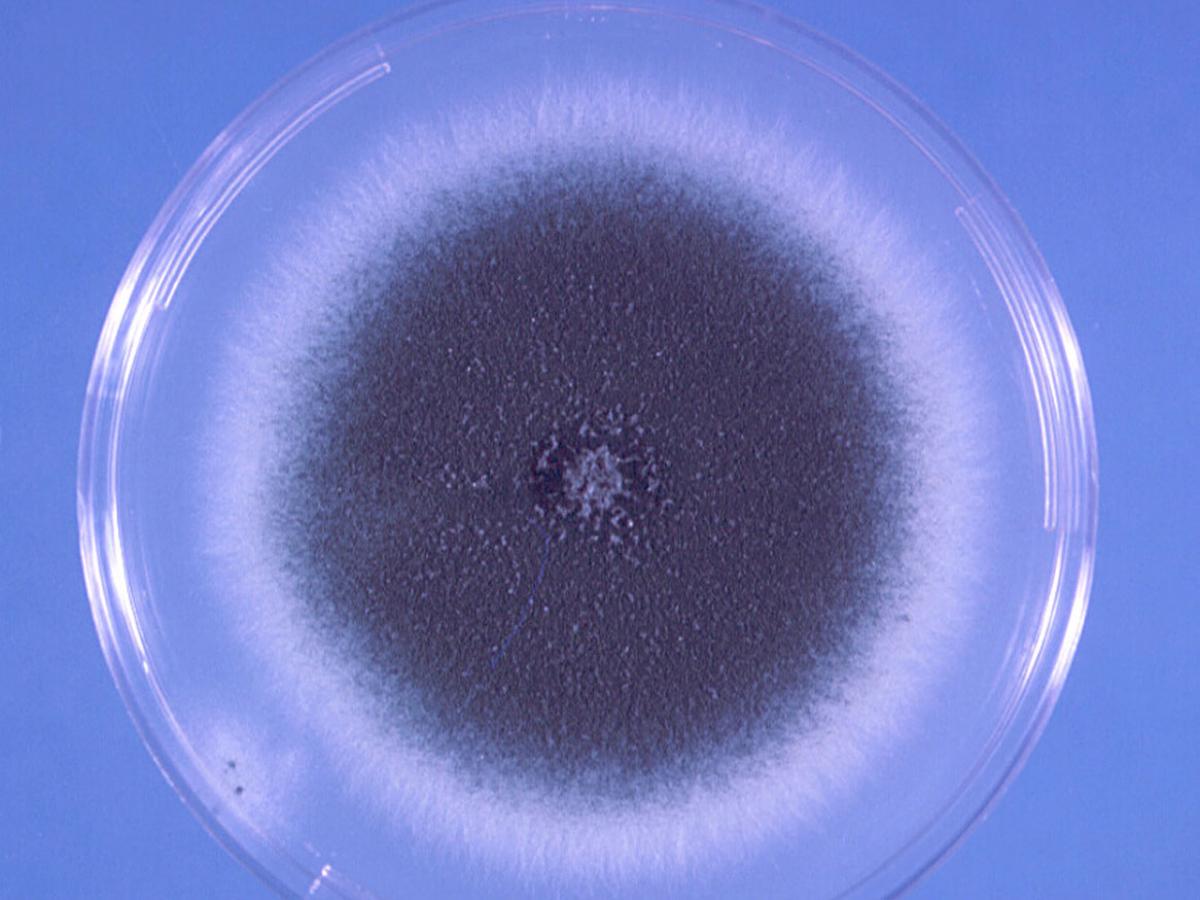
Culture

Unknown 41
Mould identification: a virtual self assessment
Case history
A 35-year-old retired painter with chronic myeloid leukaemia complicated by acute graft-versus-host disease developed a necrotising pneumonia with a bronchopleural fistula. Lobectomy showed the presence of filamentous hyphae and the culture below was isolated.

Direct microscopy

Direct microscopy
Culture

Microscopy

Microscopy